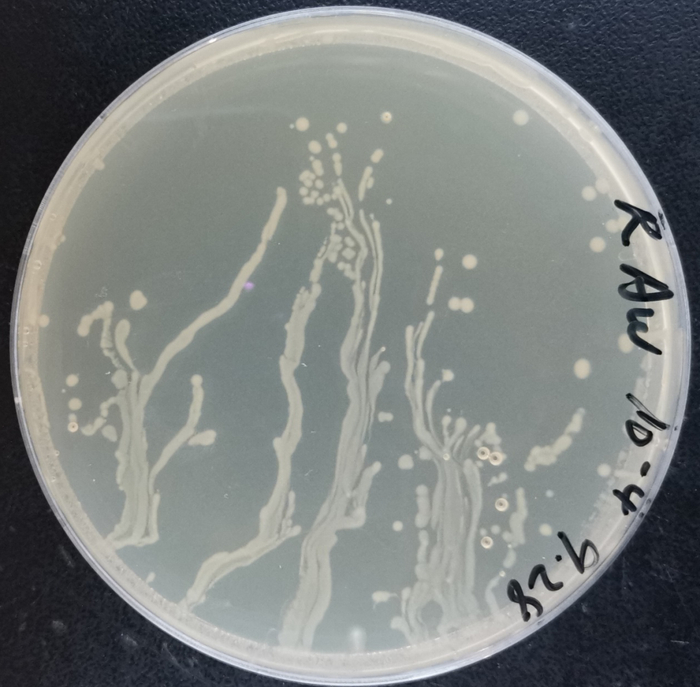

原标题:咔嚓!定格最最最最美科研!
来源:北京科技大学“科研”
向来不是枯燥乏味的代名词
科研的迷人之处
恰是细节之处的惊喜——
你是否
见过晶体在显微镜下的层峦叠翠?
见过菌落在表面皿上的肆意生长?
见过光子在那光路中的曼妙起舞?
又或者是
川西高原上小孩子们的求知脸庞
实验室里队员们通宵的备赛日常
三星堆遗址古今文明的奇妙碰撞
……
本次“科研最美瞬间”摄影大赛活动
经过一个月的校院层层选拔
共有20位选手,携着佳作脱颖而出
他们定格下
科研过程中的最美瞬间!
就让我们一起看看
这些摄影师眼中不一样的科研世界吧!
01
锥形瓶里的黑洞

01
作品介绍
一个普通的试验,锥形瓶里是钕铁硼的浸出液,溶液的透光度不高,在瓶底通过手电筒打光,然后从瓶口向下拍。结果还挺惊艳的,呈现出了一环一环的光晕,和2019年人类首次拍到的黑洞照片颇为相似,希望大家都能发现平凡生活美的瞬间。
——肖福生 矿加硕2004
土木与资源工程学院
02
微观世界中的“星球”


01
作品介绍
一个普通的试验,锥形瓶里是钕铁硼的浸出液,溶液的透光度不高,在瓶底通过手电筒打光,然后从瓶口向下拍。结果还挺惊艳的,呈现出了一环一环的光晕,和2019年人类首次拍到的黑洞照片颇为相似,希望大家都能发现平凡生活美的瞬间。
——肖福生 矿加硕2004
土木与资源工程学院
02
微观世界中的“星球”
(修饰后)
03
作品介绍
照片是使用化学气相沉积法在氧化硅表面生长的氧化锌纳米结构的SEM图像,密集的芦苇荡,因此照片取名为“冲出迷途”。科研经历往往不会一帆风顺,同学们在知识的茫茫丛林中可能会迷失方向甚至搁浅,但是不能放弃希望,努力地坚持下去,终究会冲出迷途,走向希望!祝大家都能像图中搁浅的小船一样冲出迷途!
——洪孟羽 先进低维材料研究室
材料科学与工程学院
04
神奇的光


(修饰后)
03
作品介绍
照片是使用化学气相沉积法在氧化硅表面生长的氧化锌纳米结构的SEM图像,密集的芦苇荡,因此照片取名为“冲出迷途”。科研经历往往不会一帆风顺,同学们在知识的茫茫丛林中可能会迷失方向甚至搁浅,但是不能放弃希望,努力地坚持下去,终究会冲出迷途,走向希望!祝大家都能像图中搁浅的小船一样冲出迷途!
——洪孟羽 先进低维材料研究室
材料科学与工程学院
04
神奇的光
04
作品介绍
平淡的自然光线在三棱镜的折射下被“拆解”为不同波长的光,每束光释放着属于自己不同频率的光芒和色彩。虽然色彩各异,但却共同构成了绚丽多彩的光谱,展示出独一无二的自然魅力,向人类生动地描绘了光的神奇,吸引着我们不懈地去拾取自然的贝壳,去探索自然的奥秘,揭示物理现象背后的自然规律。
保持一份最初的好奇心,坚定走下去,不断努力,不断尝试,愿每个科研人都能做一个勇敢的追光者!
——张海峰 机研2106
机械工程学院
05
婉若游龙

05
作品介绍
当改性生物炭放大500倍,宛若深海游龙,在废水里负重(重金属)前行的同时,仍不忘吞噬着环境中的污染物,用自身的千疮百孔,换取一湾碧水。
——刘陈静 能环博17
能源与环境工程学院
06
忘我造就极致

06
作品介绍
摄影作品拍摄于高工楼312实验室,记录了北京科技大学Reborn机器人战队的队员们的备赛日常。
照片名为《忘我造就极致》,照片中一位队员席地而坐,忘我地调试机器人的代码。为了让机器人在明年的比赛中能有更出色的表现,队员们需要不断的调试代码,发现问题进行改进,最终才能造就一个极致的机器人。
——巨柳荫 自1802班
自动化学院
07
水下双工百兆以太网通信

07
作品介绍
目前,海洋资源丰富,水声通信却存在严重的信号衰减、传输速率低的现象。我们在机电楼可见光通信实验室,应用水下吸收窗口比较小的蓝绿光波段搭建了光通信链路,实现了高速率、低衰减的效果。完成了水下双工的百兆传输,满足水下传输视频、音频等一系列应用,甚至能做到看直播都不卡顿。
——冯丽雅 研2001
计算机与通信工程学院
08
抓不住的光

08
作品介绍
光学中最美的一部分就是看到光路沿着自己设计的路线完成它的使命,每一个光子激发着自己的力量,勇敢的前进,他们在烟雾的作用下曼妙地起舞,像是在歌唱自己的美丽。科研的美丽与魅力在此刻体现,虽然我们抓不住光,但是我们可以看到他们的欢呼雀跃,生机勃勃。
——赵夕渊 硕1903
数理学院
09
平板花世界

06
作品介绍
摄影作品拍摄于高工楼312实验室,记录了北京科技大学Reborn机器人战队的队员们的备赛日常。
照片名为《忘我造就极致》,照片中一位队员席地而坐,忘我地调试机器人的代码。为了让机器人在明年的比赛中能有更出色的表现,队员们需要不断的调试代码,发现问题进行改进,最终才能造就一个极致的机器人。
——巨柳荫 自1802班
自动化学院
07
水下双工百兆以太网通信

07
作品介绍
目前,海洋资源丰富,水声通信却存在严重的信号衰减、传输速率低的现象。我们在机电楼可见光通信实验室,应用水下吸收窗口比较小的蓝绿光波段搭建了光通信链路,实现了高速率、低衰减的效果。完成了水下双工的百兆传输,满足水下传输视频、音频等一系列应用,甚至能做到看直播都不卡顿。
——冯丽雅 研2001
计算机与通信工程学院
08
抓不住的光

08
作品介绍
光学中最美的一部分就是看到光路沿着自己设计的路线完成它的使命,每一个光子激发着自己的力量,勇敢的前进,他们在烟雾的作用下曼妙地起舞,像是在歌唱自己的美丽。科研的美丽与魅力在此刻体现,虽然我们抓不住光,但是我们可以看到他们的欢呼雀跃,生机勃勃。
——赵夕渊 硕1903
数理学院
09
平板花世界
09
作品介绍
菌落形成的花朵姿态妖娆,弯弯曲曲的“树干”上长出星星点点“白色小花”。她们相互簇拥肆意生长,仿佛展现出生命的顽强向上。这些弯曲的“树干”其实是含有细菌的水滴划过培养基表面留下的生长印记,而“白色小花”则是细菌形成的肉眼可见的单克隆菌落。
——刘超 化博19班
化学与生物工程学院
10
舍得之间

10
作品介绍
舍得两字是股票、基金和期货投资的精华,在我看来,做科研与股票投资是一样的,热门的研究方向可能是未来发展的方向,也可能只是昙花一现。结合自身的性格、爱好,领会本学科发展的特点,仔细的观察社会发展的需要,认真思考自己所从事的科研与科学问题或者社会需求的关系,反思自己走过的足迹,在舍得之间做出自己理性的分析,或许对决定自己将来从事的科研方向有着莫大的好处。
——赵朔 国贸192
经济管理学院
11
川西之光

11
作品介绍
这是我在阿坝县龙藏小学支教时所摄。阿坝是一片位于青藏高原东南部辽阔、神圣的净土。这里的每一个孩子脸上都洋溢着天真、淳朴的笑容,然而落后的经济、教育却无法满足孩子们对知识和世界的渴望。他们心中有梦,眼里有光,我会持续尽己所能用社工专业所学帮助大山里的孩子们得到更多关注,陪他们一起追梦、寻光。
——张子圆 研21级社会工作
文法学院
12
求得经典,是得真知

12
作品介绍
首夏犹清和,芳草亦未歇。夏初,充满生机的季节与读书为伴,与真知同行。科大马院求是学会带着思想走入书籍,依靠文化,持续领会文字的力量。读书会的举办让我们在喧嚣的社会中带领我们在文字中探索成长的方向,发展的能量。在思潮涌动的今天,我们带着问题在茫茫书海进行阅读,与同窗共同交流探索是提升自己、净化心灵首要的路径。愿我们领会求是精神,在读书中求得经典,是得真知!
——徐晓琪 思政研20
马克思主义学院
13
脑电实验


10
作品介绍
舍得两字是股票、基金和期货投资的精华,在我看来,做科研与股票投资是一样的,热门的研究方向可能是未来发展的方向,也可能只是昙花一现。结合自身的性格、爱好,领会本学科发展的特点,仔细的观察社会发展的需要,认真思考自己所从事的科研与科学问题或者社会需求的关系,反思自己走过的足迹,在舍得之间做出自己理性的分析,或许对决定自己将来从事的科研方向有着莫大的好处。
——赵朔 国贸192
经济管理学院
11
川西之光

11
作品介绍
这是我在阿坝县龙藏小学支教时所摄。阿坝是一片位于青藏高原东南部辽阔、神圣的净土。这里的每一个孩子脸上都洋溢着天真、淳朴的笑容,然而落后的经济、教育却无法满足孩子们对知识和世界的渴望。他们心中有梦,眼里有光,我会持续尽己所能用社工专业所学帮助大山里的孩子们得到更多关注,陪他们一起追梦、寻光。
——张子圆 研21级社会工作
文法学院
12
求得经典,是得真知

12
作品介绍
首夏犹清和,芳草亦未歇。夏初,充满生机的季节与读书为伴,与真知同行。科大马院求是学会带着思想走入书籍,依靠文化,持续领会文字的力量。读书会的举办让我们在喧嚣的社会中带领我们在文字中探索成长的方向,发展的能量。在思潮涌动的今天,我们带着问题在茫茫书海进行阅读,与同窗共同交流探索是提升自己、净化心灵首要的路径。愿我们领会求是精神,在读书中求得经典,是得真知!
——徐晓琪 思政研20
马克思主义学院
13
脑电实验
13
作品介绍
第一次进入我们学院的脑电实验室,有幸做了被试,带上了脑电帽,头上插满了脑电接头。由于头发并不茂密,刚戴好设备电路就显示良好,屏幕一片美好的绿色,只有一块是显示红色。于是工程师解释说道,是由于脑电帽拉伸,接头之间距离太远,于是又教我们如何固定距离。在她细心的指导下,我们学会了如何使用脑电程序和脑电设备,是一次很有收获的实验室亲身实践。
对于脑电实验来说,绿色就是最美的颜色,对于我来说,脑电帽五彩的颜色也是最美的颜色…
——朱张晨曦 外研21
外国语学院
14
另一个世界的美

14
作品介绍
这张图片为SRTP项目实验所拍摄。利用超景深显微镜对不同颜色不同老化状态下的彩画进行更加微观的观察,蓝色颜料显示出如蓝宝石般的小颗粒。就像一个人,从外表看起来平平无奇,但内心却十分有趣。
——杨景全 高工1904
高等工程师学院
15
疾风劲草

15
作品介绍
疾风劲草:是在Al50Ni50合金甩带片(黄色)上生长的小纳米片(绿色)。合金基底虽然很坚硬,但零零散散的纳米片还是以顽强的毅力“破土而出”。让人不禁想到唐代诗人白居易《赋得古原草送别》中的诗句:“离离原上草,一岁一枯荣。野火烧不尽,春风吹又生。”
——陈磊磊 博21
新金属材料国家重点实验室
16
钻石里的山水画


14
作品介绍
这张图片为SRTP项目实验所拍摄。利用超景深显微镜对不同颜色不同老化状态下的彩画进行更加微观的观察,蓝色颜料显示出如蓝宝石般的小颗粒。就像一个人,从外表看起来平平无奇,但内心却十分有趣。
——杨景全 高工1904
高等工程师学院
15
疾风劲草

15
作品介绍
疾风劲草:是在Al50Ni50合金甩带片(黄色)上生长的小纳米片(绿色)。合金基底虽然很坚硬,但零零散散的纳米片还是以顽强的毅力“破土而出”。让人不禁想到唐代诗人白居易《赋得古原草送别》中的诗句:“离离原上草,一岁一枯荣。野火烧不尽,春风吹又生。”
——陈磊磊 博21
新金属材料国家重点实验室
16
钻石里的山水画
16
作品介绍
超厚单晶金刚石既可用于国防又可用于钻石首饰。通过人造的方法(如高温高压或者化学气相沉积),在晶种上外延生长大尺寸、高质量单晶金刚石,通过一定晶向的打磨与加工,便成为众人推崇的璀璨的钻石。其中化学气相沉积法会在晶种周围生长黑色的多晶金刚石。本作品是在化学气相沉积法制备钻石毛坯过程中,对单晶金刚石晶种周围生长的黑色多晶金刚石进行切割与抛光后的光学显微镜照片,看起来像远处层峦叠嶂的山倒映在湖里的景象。
——刘金龙 碳基材料与功能薄膜研究室
新材料技术研究院
17
大国重器

17
作品介绍
照片为国科中心力学厂中30000kN拉压疲劳试验机,两位同学正在进行做试验的前期准备工作。该装置可以进行大/全尺寸材料或构件强度与疲劳性能试验,目前大尺寸/全尺寸材料或构件在多场耦合环境下服役性能的综合评价试验,已达到国际一流水平。试验机器虽然没有温度,但热爱科研之心熠熠发光,在国科这个大家庭中,我们将秉承求实鼎新的校训精神,带着满腔热忱与大国重器为伍,与数据、代码为伴,砥砺前行,为国家重大工程材料的服役安全贡献北科力量。
——张琬滢 国科硕2003班
国家材料服役安全科学中心
18
神鸟栖扶桑

18
作品介绍
戴上工作证、穿上防护服,拉开发掘舱被水汽模糊的舱门,记录好舱内的温湿度和参与发掘人员的信息,今天的发掘从提取编号XXX的器物开始,刷子、手铲、竹签、高分子绷带……是科技和文物的结合。遇上休息日,就去博物馆逛逛,为日后的发掘汲取营养。千年前,先民们用铜与火碰撞,铸造出一件件精妙绝伦的器物;现如今,考古工作者用手铲和科技的结合,述说一个个引人入胜的故事。你好堆堆,很高兴认识你。
——曾晓天 科技史硕20
科技史与文化遗产研究院
19
本质


19
作品介绍
这组图是钛合金经固溶时效处理后的衬度对比图和取向成像图。本来色泽单调的你只是万千晶粒中的普通一员,而EBSD技术赋予你多彩颜色,代表你的个性特征,让我们更加清楚认识你的本质世界。
——潘宇 工研博18班
工程技术研究院
20
万花丛中一枝独秀

20
作品介绍
无论在宏观尺度,还是微观尺度下,科研的美都是无处不在的。通过特定的科研手段,就可操控微观尺度下的物质形貌,生成很多美丽的图案。该图为扫描电镜下的纳米材料,图中的大晶粒为CdS分子长成的枝晶,犹如在万花丛中的一枝独秀。而在科研中,也只有足够优秀的人才能在科研的大军中傲立群雄,成为科研领军人物!
——方志 协创博16
钢铁共性技术协同创新中心
“科研最美瞬间”
离不开一双双发现美的眼睛
和一位位专注的最美科研人
科研的道路纵使一路艰辛
但愿大家也能去感受路途中的点点美好
接下来
请大家选出心中的“科研最美瞬间”吧!
投票截止时间为
12月5日


